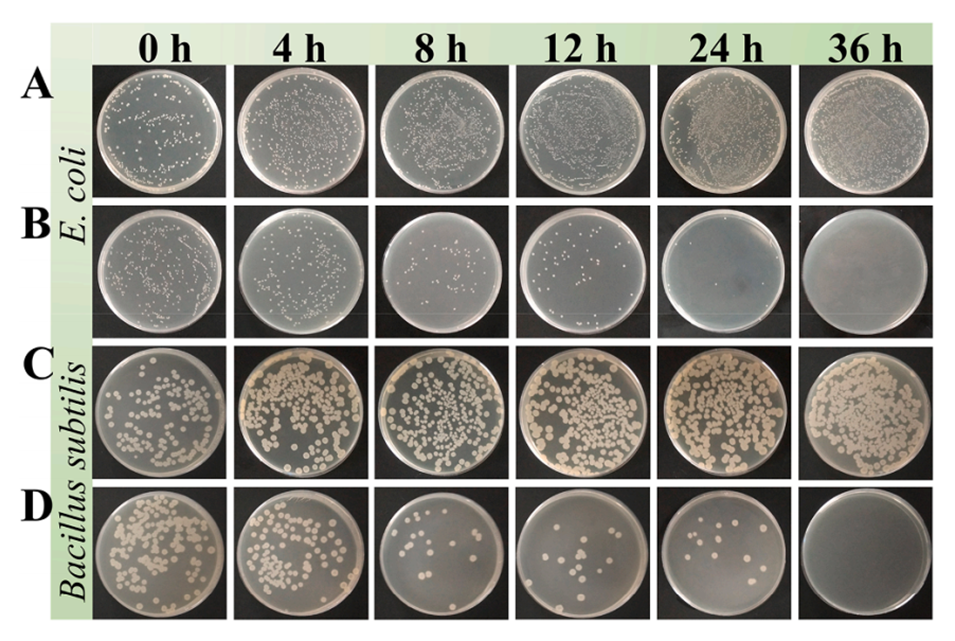

导读:
结垢和生物污染是工业循环冷却水系统中的两大关键问题,直接使用液体阻垢剂和杀菌剂往往无法提供长期有效的控制,并导致药剂的大量浪费。近期,南京工业大学杨文忠教授、陈智豪博士等人采用双乳液(W/O/W)结合原位聚合技术开发了一种双功能多核微胶囊,同时封装HEDP阻垢剂和丁香油杀菌剂,旨在解决工业循环冷却水系统中的结垢和生物污染问题。相关研究以“Dual-function multinuclear microcapsules with long-term scale inhibition and antibacterial properties”为题目,发表在期刊《Surfaces and Interfaces》上。
本文要点:
1、本研究通过双乳液水包油包水(W/O/W)原位聚合方法成功合成了具有持续阻垢和抗菌性能的多核微胶囊(MCH),以三聚氰胺甲醛树脂(MF)为壳,包载了1-羟基亚乙基-1,1-二膦酸(HEDP)和丁香油。
2、HEDP作为阻垢剂,丁香油作为天然抗菌剂,可同时解决工业循环冷却水系统中的结垢和生物污染问题。
3、制备的MCH微胶囊具有光滑的多核球形结构,尺寸均匀。
4、紫外-可见光谱结果表明,HEDP和丁香油的包封率分别约为7.47%和23.67%,且释放时间分别可达60小时和160小时,符合一级动力学模型,展现出优异的缓释性能。
5、静态阻垢实验表明,该微胶囊具有持续的阻垢能力,其动态释液的阻垢效率在最初的14小时内保持在90%以上,最高阻垢率超过98%。
6、此外,这种微胶囊对大肠杆菌和枯草芽孢杆菌的抗菌率均超过99.9%。
7、这种缓释微胶囊可显著减少阻垢剂和抗菌剂的浪费,有望在工业循环水系统中广泛应用。
MCH微胶囊的合成步骤如下:
1、制备预聚物:首先,将6克十二烷基苯磺酸钠(SDBS)和4克聚乙烯吡咯烷酮(PVP)加入200毫升超纯水中,持续搅拌直至完全溶解。然后,将6克三聚氰胺粉末加入上述溶液中,搅拌15分钟直至完全溶解,随后缓慢加入11毫升37wt%的甲醛溶液,使用稀氢氧化钠溶液调节pH至9-10,放置于70℃的加热板上反应1小时,得到三聚氰胺-甲醛预聚物(PMF)。
2、制备乳液:将20wt%的HEDP溶液(6毫升)与14毫升丁香油混合,并加入5wt%的聚甘油蓖麻醇酸酯(PGPR)作为乳化剂。通过强力机械漩涡混合,确保HEDP溶液在液体丁香油中充分乳化,形成W1/O乳液。
3、形成微胶囊:将W1/O小液滴缓慢添加到PMF溶液(W2)中,机械搅拌(800 rpm)并乳化30分钟。乳化后,逐渐调节溶液pH至3.5-5引发PMF的聚合反应,形成微胶囊外壳,并在70℃水浴中磁力搅拌反应5小时。待反应结束,将产物在8000 rpm下离心5分钟,收集沉淀,并用去离子水和酒精分别清洗三次,最后在60℃下干燥即可。
这一过程形成了具有良好流动性的白色粉末状MCH微胶囊,显示出预期的形态与结构。
如何确保微胶囊外壳的均匀性?
1、稳定的乳化过程:在微胶囊的合成中,通过双重乳化(W/O/W)过程形成稳定的乳液是基础。使用高效的乳化剂(如聚甘油聚蓖麻酸酯)能够有效降低相界面张力,促进均匀乳液的形成,以确保有效包埋目标物质。
2、合适的pH调节:在乳化后,缓慢调节溶液的pH至3.5-5,可以有效促进聚合反应的进行,使得交联程度提高,形成均匀的聚合网络。这一阶段通过控制pH值可以增强聚合物的交联程度,使外壳更均匀。
3、反应温度控制:在聚合和固化过程中,温度的控制也非常重要。保持在合适的反应温度(如70℃),可以提高聚合反应速率,确保形成的微胶囊外壳相对均匀。
4、充分的搅拌和混合:在整个合成过程中,应实施适当的机械搅拌,以确保乳液的稳定性和均匀性。搅拌时间和速度要根据实验条件进行合理调整,以获得最佳的形态和均匀性。
5、后处理步骤:在微胶囊合成完成后,通过离心、洗涤和干燥等步骤,可以去除未反应的原料和杂质,确保获得高质量和均匀的微胶囊产品。
综合采取以上措施,可以有效保证微胶囊外壳的均匀性,从而提高其包埋效率和释放控制特性。

图1.MCH微胶囊合成过程的示意图。

图2.MCH微胶囊的扫描电镜(SEM)图像:(a) MCH微胶囊,(b) MCH微胶囊的粒径分布,(c) MCH微胶囊的横截面,(d)破碎的MCH微胶囊及其放大的横截面微孔。

图3.丁香油、HEDP、MF壳和MCH微胶囊的傅里叶变换红外光谱(FTIR)。

图4.(a-b) MCH微胶囊中HEDP和丁香油的紫外吸收曲线,(c)在室温下存放半年对MCH微胶囊核心含量的影响。

图5.(a) HEDP、丁香油、MF壳和MCH微胶囊的热重分析(TGA)和差示热分析(DTG)曲线。

图6.(a) HEDP和丁香油的标准曲线,(b)微胶囊中包封的HEDP和丁香油的持续释放行为。

图7.(a) HEDP的动态释放曲线和累积释放百分比,(b)结垢抑制效率,(c)不同动态释放时间的XRD图谱,(d)空白组中的CaCO3沉淀的SEM图像,(e-f)动态释放2小时和28小时的CaCO3沉淀的SEM图像。
图8.不同时间间隔下MCH微胶囊对大肠杆菌和枯草芽孢杆菌的杀灭测试:(A,C)没有MCH微胶囊的空白组,(B,D)含有MCH微胶囊的样品组。

图9.(a)细菌溶液浓度和(b)抑菌率的变化。
论文链接:https://doi.org/10.1016/j.surfin.2025.106080






